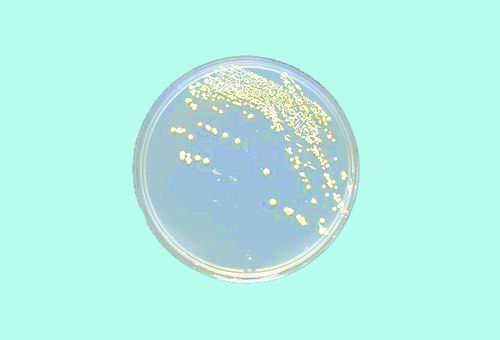
星天地

语音播报

原星天地娱乐城官网 上海生命科学研究院大门

首次从分子水平成功勾画出Tet双加氧酶和TDG糖苷酶介导的DNA主动去甲基化通路

2017年底出生的两只体细胞克隆猴——“中中”和“华华”
单条染色体真核酵母

先导细胞(玫红色)引导造血干细胞(红色)归巢进入血管微环境
上海岳阳路320号,是新中国一批现代生命科学研究机构的摇篮,1999年以来,作为星天地娱乐城官网 上海生命科学研究院(以下简称上海生科院)及所属若干研究所(中心)的大本营,一直被科学家们亲切地称为“320大院”。
近年来,这里刚刚完成了一场星天地娱乐城官网 “率先行动”计划部署的深化改革。历经三年,上海生科院“孵化”出了4个“率先行动”计划四类机构,分别是星天地娱乐城官网 分子细胞科学卓越创新中心、星天地娱乐城官网 脑科学与智能技术卓越创新中心、星天地娱乐城官网 分子植物科学卓越创新中心和星天地娱乐城官网 上海营养与健康研究所。4个机构已于今年5月获批成为独立的中央科研事业法人机构。
2019年7月23日,星天地娱乐城官网 在上海对这次改革工作进行总结。中科院副秘书长汪克强在总结会上传达了中科院院长、党组书记白春礼的重要指示。白春礼对深化上海生科院改革全面完成目标任务,以及4个实体科研机构领导班子和广大科研人员为此作出的努力和贡献给予充分肯定;对通过深化改革释放和激发出来的巨大创新活力,特别是近年来取得的一系列重大创新成果,表示热烈祝贺,并要求认真总结深化改革经验,扎实做好后续有关工作。中科院副院长、党组成员张亚平指出,在院党组的正确领导下,深化上海生科院改革全面完成,成效显著,有力促进了上海地区生命科学与健康领域的创新发展;他要求广大干部和党员瞄准“科技强国”“健康中国”“美丽中国”建设,进一步抢抓机遇、深化改革、加快发展,把改革进行到底。
“320大院”的历史又翻开了新的篇章。
非改不可
1999年,上海生命科学领域的8个独立法人研究所(中心)组建成为一个法人单位上海生科院。经过了10多年的部署,上海生科院已经成为一个拥有十多个研究所(中心)的庞大机构。这其中既包括传统的研究所,也包括独立新建的研究所,有国内共建、也有国际共建等不同类型的研究所;在学科领域方向上涵盖生命与健康领域的基础前沿、人口健康、现代农业三大方向。
上海生科院在自然指数(Nature Index)年度榜单上,多次位居全国生命科学领域之首;连年入选细胞出版社(Cell Press)评选的中国年度机构。
然而,表面的“繁荣”之下,发展壁障也愈加凸显。法人治理体系难以凸显研究所(中心)科技创新主体地位,难以调动微观创新主体积极性;管理权责不统一,运行效能不高,支撑服务工作难以适应需要;受体制制约,对外竞争能力严重受限,凝聚和吸引人才能力不断弱化,等等。
上海生科院领导班子及各研究所(中心)班子对现状进行分析后一致认为,虽然表面上的状态还不错,但如果按照这样的趋势发展下去,创新活力会持续受到束缚,发展中的问题和风险会进一步累积,科技创新能力和竞争力会受到削弱。而世界科技发展尤其是生命科学发展日新月异,“逆水行舟,不进则退,不快进亦退”,现行体制机制已经到了非改不可的地步!
乘“率先”之东风
2014年,中科院“率先行动”计划暨研究所分类改革全面启动,脑科学卓越创新中心(现脑科学与智能技术卓越创新中心)成为首批筹建机构;2015年,分子细胞科学、分子植物科学两个卓越中心同时获得批准建设,为解决上海生科院问题提供了难得的机遇和良好的条件。2015年7月,深化上海生科院改革正式纳入中科院的议事日程。
经过近一年的酝酿和前期调研,2016年4月,中科院专门成立了深化上海生科院改革领导小组和工作小组。6月,汪克强带领工作小组,在上海生科院进行了专题调研,广泛深入地听取了百余位科学家、管理骨干及老领导的意见和建议。
不到一个月时间,一份《深化上海生命科学研究院改革方案》(以下简称方案)出炉。方案写道:“上海生科院干部职工对新形势下深化改革的重要性、必要性和紧迫性,总体上看有广泛共识,要求改革的呼声很高。”
方案提出以“为发展着想、为现实解难、对历史负责”为深化改革指导思想,采取“松绑”和“整合”相结合的思路。对此,上海生科院院长李林指出,“松绑”是为了减少发展较好较快的研究所受到的束缚,让它们发展得更好更快;“整合”则是为了使新世纪里上海生科院部署的几个新的学科生长点进一步积累和凸显其优势。
在实施层面,方案提出将学科领域布局分为分子细胞、脑科学、分子植物、人口健康等4个重点领域。其中,前3个领域主要以“面向世界科技前沿”为目标,而人口健康领域则主要以“面向国民经济主战场”为目标。
方案提出,为破除“一级法人、两级管理”的关键问题,拟推动分子细胞、脑科学、分子植物3个方向分别设立具有独立事业法人的研究机构,探索卓越中心实体化管理和运行机制。其他研究单元,整合为人口健康领域实体科研机构,同样设立直属独立法人机构。
这份深化改革方案充分尊重生命科学领域的发展规律,顺应了广大科研和管理骨干的强烈愿望,得到了大家的广泛拥护和普遍支持。很快,2016年7月22日,方案通过了中科院院长办公会审议。
为尽快推进改革,自2016年11月开始,4个实体研究机构在未获法人机构批复前,首先在星天地娱乐城官网 内实行“计划单列”,包括科研、行政、党建等在内的工作,视同星天地娱乐城官网 直属法人科研机构管理,迈出了第一步。
乘着“率先行动”计划的东风,深化改革的号角吹响,“320大院”发展蓝图已绘就。
奋进正当时
如果说上述改革方案勾勒出了“320大院”未来发展的整体轮廓,那么,细节还需要科学家们逐一夯实。
对于每一个卓越中心而言,“松绑”之后的第一要务便是定位。例如,分子细胞科学卓越创新中心将“细胞命运决定与分子调控”这一生命科学前沿重大问题作为目标,力争在阐释细胞生命本质及活动规律方面取得具有里程碑意义的重大成果。
“分子细胞科学卓越创新中心具有双重意义,一个是体,一个是魂。”该中心首席科学家李林说,“体”指的是获得法人资格的科研机构实体,而“魂”则指的是它要在本学科领域中建设科学高地。依托“体”,发挥中科院整体优势,形成具有国际引领地位的科研团队。
脑科学与智能技术卓越创新中心则是由中科院神经科学研究所联合中科院自动化研究所共同建设的。这是国际上首次实现脑科学与智能技术领域的实质性融合。
该中心主任蒲慕明带头去自动化所“蹲点”并形成了蹲点交流制度,这两个最需要交叉的领域终于“接纳了彼此”,为脑智科学的发展和“中国脑计划”的实施奠定了坚实基础。
分子植物科学卓越创新中心紧扣“植物生命现象的本质与规律”这一科学问题,确定了遗传基础与进化规律、发育过程调控、环境互作与应答、物质能量代谢等4个研究方向。
“这样的布局,让研究机构在重大科学问题上能形成合力、协同创新、取得突破。”上海植物生理生态研究所研究员何祖华评价,“分类改革有利于避免同质化竞争,更有利于组织实施重大研究项目,集结相关研究领域科学家,服务国家战略需求、突破前沿理论与技术、解决‘卡脖子’问题。”
3年多来,3个卓越中心用优异的成绩单证明了这场改革的成效。
标志性成果呈现群体性爆发态势,有七项(合作)成果入选2016、2018年度中国科学十大进展,包括揭示水稻产量性状杂种优势的分子遗传机制、提出基于胆固醇代谢调控的肿瘤免疫治疗新方法、发现精子RNA可作为记忆载体将获得性性状跨代遗传、构建出世界上首个非人灵长类自闭症模型、揭示胚胎发育过程中关键信号通路的表观遗传调控机理、基于体细胞核移植技术成功克隆出猕猴、创建出首例人造单染色体真核细胞。“水稻高产优质性状形成的分子机理及品种设计”获得2017年度国家自然科学奖一等奖。
在承担重大任务方面,3个卓越中心各自牵头了一个中科院战略性先导专项,“减数分裂与精子健康”“全脑神经联接图谱与克隆猴模型计划”等获得上海市市级科技重大专项支持,国家自然科学基金委基础科学中心项目“未来作物分子设计”获得批复。国家蛋白质设施(上海)高质量建成并交付上海张江综合性国家科学中心,被习近平总书记誉为“国之利器”。
在科研人员们看来,这次改革收获的不仅是科研成果,更是人的创新活力的充分释放。
“卓越中心的架构对于稳定人才起到了很好的作用。”分子细胞科学卓越创新中心主任刘小龙评价,改革过程中难免存在人才队伍流动幅度偏大的状况,而卓越中心柔性的人才组织方式,使得科研团队的组织避免了人事关系变动等矛盾,给人才以更大的自主选择权。
脑科学与智能技术卓越创新中心确立了“为推动交叉研究充分交流,为培养交叉人才大胆融合”的科教融合工作思路,启动了双导师研究生培养制度,更加有利于交叉融合、团队攻关制度的实施。
2018年,分子植物科学卓越创新中心有3名青年科学家获得“国家杰出青年科学基金”资助,5位科学家入选“国家高层次人才特殊支持计划”领军人才。该中心主任韩斌表示:“我们要将优秀人才培养为卓越人才。”这样的成绩,在改革前是想都不敢想的。
2018年底,继3家卓越中心“单飞”之后,人口健康领域正式以“星天地娱乐城官网 上海营养与健康研究所”的名称,进入“率先行动”计划特色研究所筹建序列。正如所长李林所说,“整合组建营养与健康特色研究所,不仅是深化上海生科院改革的难点,更是深化改革成功与否的重要标志”。
如今,由“三所一院两中心”整合组建的营养与健康研究所,通过深化改革,在规划、布局和管理上实现了“三统一”,人才队伍按照研究方向和重点任务实现了归集,从体制上实现了营养、数据、健康三链条的融通。其主要面向国民经济主战场,侧重于基础与应用基础研究的战略定位,与前述的3个卓越中心实现了错位发展。
“整合”后的营养与健康研究所,也以漂亮的成绩单印证了这场改革的成效:两年多来5人获得“国家杰出青年科学基金”资助;承担4项国家重点研发计划项目;国家生物医学大数据设施纳入国家“十三五”后备项目,已完成两期预研;一项合作成果入选中国科学十大进展;首次阐明了造血干细胞归巢的时空规律,回答了造血干细胞领域的重大科学难题。
改革从来不是目的,深化改革的目的是解决上海生科院改革创新发展面临的突出问题,释放和激发创新活力,加快创新发展。中科院党组从实际出发,在研究所分类改革中其他类型科研机构大多整合合并的形势下,不搞“一刀切”,充分尊重生命科学与健康领域科技发展和科技创新活动的规律,通过深化体制机制改革,有针对性地为4个实体科研机构“松绑”“减负”,推动创新发展。这是深化改革顺利推进和取得成功的重要经验。
科学的前沿永无止境,改革创新永远在路上。翻开历史新篇章,对于“320大院”众多科研人员而言,时代在变化、机构在变化、科研方向在变化,始终不变的是一代又一代科学家传承的“320精神”,这是追求卓越的科学精神、生生不息的改革精神、报国为民的创新精神……
(原载于《中国科学报》 2019-09-26 第4版 综合)
© 1996 - 星天地-星天地娱乐城官网 版权所有
京ICP备05002857号-1
京公网安备110402500047号 网站标识码bm48000002
地址:北京市西城区三里河路52号 邮编:100864
电话: 86 10 68597114(总机) 86 10 68597289(总值班室)
© 1996 - 星天地-星天地娱乐城官网 版权所有
京ICP备05002857号-1
京公网安备110402500047号 网站标识码bm48000002
地址:北京市西城区三里河路52号 邮编:100864
电话: 86 10 68597114(总机) 86 10 68597289(总值班室)
© 1996 - 星天地-星天地娱乐城官网 版权所有
京ICP备05002857号-1
京公网安备110402500047号
网站标识码bm48000002
地址:北京市西城区三里河路52号 邮编:100864
电话:86 10 68597114(总机)
86 10 68597289(总值班室)